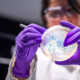
Dan po Romuniji gobavost potrdili tudi na Hrvaškem

Prvi primer gobavosti po več desetletjih na Hrvaškem so epidemiologi potrdili pri državljanu Nepala v Splitu. Oseba se je s simptomi gobavosti na splitskem epidemiološkem oddelku pojavila pred približno 10 … · Dnevnik · 3h

Košarkarji Cedevite Olimpije so hitro našli odgovor na poraz sredi tedna v evropskem pokalu, s katerim so prekinili niz osmih zmag v vseh tekmovanjih. V dvorani Tivoli so premagali Bosno … · Dnevnik · 5h

V Siriji sta bila v napadu na konvoj ameriških in sirskih sil med skupno patruljo ubita dva ameriška vojaka in civilist. Napad je izvedel pripadnik skrajne skupine Islamska država, so … · 24ur · 4h

Atletico Madrid se je po dveh zaporednih porazih v španskem prvenstvu vrnil na zmagovalno pot. Potem ko je sredi tedna v ligi prvakov slavil pri PSV Eindhovnu, je danes pred … · Dnevnik · 5h
16. krog la liga nogomet objavi tvitaj

Slovenski deskarji se na tretjem paralelnem veleslalomu za svetovni pokal v olimpijski Cortini d'Ampezzo niso posebej izkazali. V kvalifikacijah je bila z 12. časom uspešna le Gloria Kotnik, ki pa … · RTV Slovenija · 5h
gloria kotnik rok marguč deskanje tim mastnak cortina d'ampezzo žan košir objavi tvitaj

Izpustitev 21-letnika je povzročila veliko negotovosti. 👇 Potem ko so v petek izpustili iz pripora 21-letnega osumljenca za napad na Aleša Šutarja oktobra v Novem mestu, je premier Robert Golob … · Metropolitan.si · 6h
osumljeni aleš šutar pripor napad novo mesto objavi tvitaj

Domen Prevc je bil pred tekmo v 'svojem mehurčku'. Domen Prevc je na prvi moški posamični tekmi v Klingenthalu prepričljivo zmagal, pred drugouvrščenim Stefanom Kraftom je imel kar 25,5 točke … · Žurnal24 · 6h
smučarski skoki klingenthal domen prevc objavi tvitaj